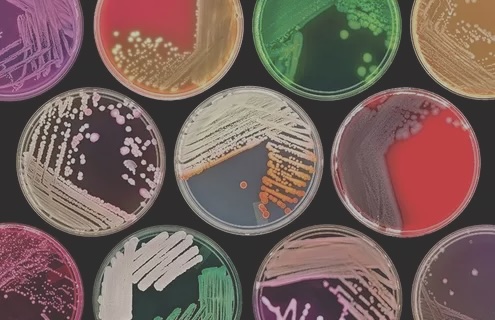

کنترل کیفی محیط های کشت میکروبی: راهنمای آموزشی کامل برای کارشناسان آزمایشگاه
کنترل کیفی محیط های کشت میکروبی فرآیندی سیستماتیک است که از انتخاب آب با کیفیت بالا شروع شده، شامل توزین دقیق مواد، حل کردن آنها، تنظیم pH، اضافه کردن مکملها، استریلیزاسیون و ارزیابی عملکرد مغذی و مهاری میشود. این روش بر اساس استانداردهای CLSI و ISO، کیفیت محیط کشت باکتریایی را تضمین کرده و دقت نتایج آزمایشگاهی را افزایش میدهد. کارشناسان با رعایت این مراحل، از آلودگی و رشد نادرست میکروارگانیسمها جلوگیری میکنند.
جهت عضویت در کانال آموزشی در تلگرام به لینک زیر مراجعه کنید:
https://t.me/hematology_education
فهرست مطالب کنترل کیفی محیط های کشت میکروبی و ارزیابی کیفیت
- مقدمه: اهمیت کنترل کیفی محیط های کشت میکروبی و استانداردهای ارزیابی
- مراحل تهیه محیط کشت: فرآیندهای استاندارد در کنترل کیفیت محیط های کشت باکتریایی
- 1. انتخاب و کیفیت آب مورد استفاده در کنترل کیفی محیط های کشت میکروبی
- 2. توزین مواد: دقت در اندازهگیری برای ارزیابی کیفیت محیط کشت
- 3. حل کردن مواد در آب: تکنیکهای مخلوط کردن در کنترل کیفی محیط های کشت
- 4. اندازهگیری و تنظیم pH: نقش pH در کیفیت محیط کشت میکروبی
- 5. اضافه کردن مکملها: غنیسازی محیط کشت برای رشد باکتریایی
- 6. استریلیزاسیون: روشهای ضدعفونی در کنترل کیفی محیط های کشت
- کنترل کیفی محیط کشت: بررسیهای فیزیکی، شیمیایی و بیولوژیکی در ارزیابی کیفیت
- بررسی فیزیکی و شیمیایی: پارامترهای ظاهری در کنترل کیفیت محیط کشت
- بررسی استریلیتی: کنترل آلودگی در محیط های کشت میکروبی
- ارزیابی عملکرد مغذی بودن: تست رشد باکتری در کنترل کیفی
- ارزیابی عملکرد مهاری: مهار رشد ناخواسته در محیط کشت
- موارد دیگر در کنترل کیفی: ذخیرهسازی و استانداردهای محیط کشت میکروبی
- نتیجهگیری: خلاصه اهمیت کنترل کیفی محیط های کشت باکتریایی
- سوالات رایج در مورد کنترل کیفی محیط های کشت میکروبی
مقدمه: اهمیت کنترل کیفی محیط های کشت میکروبی و استانداردهای ارزیابی
در آزمایشگاههای میکروبیولوژی، محیط کشت (که معادل اصطلاح انگلیسی “culture media” است) به عنوان پایهای برای رشد، جداسازی، شناسایی و مطالعه میکروارگانیسمها عمل میکند. کیفیت محیط کشت نه تنها بر دقت نتایج آزمایشگاهی تأثیرگذار است، بلکه میتواند بر تشخیص بیماریها، تحقیقات علمی و کنترل کیفیت در صنایع غذایی و دارویی نیز اثر بگذارد. هرگونه نقص در تهیه یا کنترل کیفی محیط کشت میتواند منجر به رشد نادرست باکتریها، آلودگیهای کاذب، تفسیر اشتباه نتایج یا حتی از دست دادن سویههای مهم شود. بنابراین، کنترل کیفی محیط کشت یک فرآیند سیستماتیک و مداوم است که بر اساس استانداردهای بینالمللی مانند CLSI (Clinical and Laboratory Standards Institute)، ISO 11133، و EP (European Pharmacopoeia) انجام میشود. این استانداردها الزاماتی برای مواد اولیه، فرآیند تهیه، ارزیابی عملکرد و مستندسازی تعریف میکنند.
این مقاله آموزشی، به عنوان یک راهنمای جامع برای کارشناسان آزمایشگاه، جنبههای مختلف کنترل کیفی را پوشش میدهد. ما از مواد اولیه مانند آب مورد استفاده شروع میکنیم و به مراحل توزین مواد، حل کردن آنها، تنظیم pH، اضافه کردن مکملها، استریلیزاسیون، ارزیابی فیزیکی-شیمیایی، بررسی استریلیتی، و ارزیابی عملکرد مغذی و مهاری میپردازیم. همچنین، بخشهایی مانند ذخیرهسازی، کنترل آلودگی، بررسی تاریخ انقضا، کالیبراسیون تجهیزات، و استفاده از سویههای کنترل استاندارد (مانند ATCC) را برای کاملتر شدن اضافه کردهایم. هدف این است که کارشناسان بتوانند با رعایت این اصول، از خطاهای رایج جلوگیری کنند و کیفیت آزمایشگاه را به سطح استانداردهای جهانی برسانند.
کنترل کیفی محیط های کشت میکروبی
جهت مطالعه ی جامع در زمینه ی کنترل کیفی میکروبیولوژی به لینک زیر مراجعه کنید:
کنترل کیفی میکروب شناسی: اصول، روشها و استانداردهای عملکردی
مراحل تهیه محیط کشت: فرآیندهای استاندارد در کنترل کیفیت محیط های کشت باکتریایی
تهیه محیط کشت باید در شرایط کنترلشده، با رعایت اصول GMP (Good Manufacturing Practice) و در محیطی تمیز مانند هود لامینار کلاس II انجام شود. این مراحل شامل انتخاب مواد با کیفیت بالا، اندازهگیری دقیق و رعایت ایمنی است. هر مرحله باید مستند شود تا در صورت بروز مشکل، ریشهیابی آسان باشد. در ادامه، هر مرحله با جزئیات بیشتر توصیف میشود.
1. انتخاب و کیفیت آب مورد استفاده
آب به عنوان حلال اصلی محیط کشت، باید عاری از هرگونه آلاینده شیمیایی، بیولوژیکی یا فیزیکی باشد که بتواند بر رشد میکروارگانیسمها تأثیر بگذارد. استفاده از آب شیر معمولی ممنوع است، زیرا ممکن است حاوی یونهای فلزی (مانند مس یا روی)، کلر، فلوراید، باکتریها یا اندوتوکسینها باشد که رشد باکتریهای حساس را مهار کند یا باعث نتایج کاذب شود. استاندارد CLSI توصیه میکند از آب مقطر، دیونیزه یا آب خالصشده با روش RO (Reverse Osmosis) با مقاومت الکتریکی حداقل 1 مگااهم در سانتیمتر و سطح باکتری کمتر از 10 CFU/ml استفاده شود. قبل از استفاده، آب را از نظر pH (که باید بین 5.5 تا 7.5 باشد)، رسانایی الکتریکی، شفافیت و عدم وجود رسوب بررسی کنید. همچنین، تستهای دورهای برای اندوتوکسینها (با روش LAL – Limulus Amebocyte Lysate) ضروری است، به ویژه برای محیطهای کشت سلولهای یوکاریوتی. در صورت لزوم، آب را با فیلترهای 0.22 میکرونی استریل کنید و آن را در ظروف شیشهای یا پلاستیکی استریل نگهداری نمایید. اگر آب کیفیت پایینی داشته باشد، میتواند منجر به تغییر pH محیط یا مهار رشد باکتریهای فستیدیوس شود. کارشناسان باید آب را هر ماه تست کنند و نتایج را ثبت نمایند.
2. توزین مواد: دقت در اندازهگیری برای ارزیابی کیفیت محیط کشت
توزین دقیق مواد اولیه مانند پپتون، عصاره گوشت، نمکها، قندها و آگار پایهای برای کیفیت محیط است. از ترازوهای دیجیتال کالیبرهشده با دقت حداقل 0.01 گرم استفاده کنید و کالیبراسیون را هر شش ماه یکبار توسط نهادهای معتبر انجام دهید. مواد خام باید از تامینکنندگان معتبر با گواهی کیفیت (COA) خریداری شوند که شامل اطلاعاتی مانند خلوص، شماره بچ و تاریخ انقضا باشد. توزین را در محیط خشک، بدون گرد و غبار و با استفاده از دستکش و ماسک انجام دهید تا از آلودگی جلوگیری شود. برای مثال، در محیطهای جامد مانند Nutrient Agar، غلظت آگار باید دقیقاً 1.5-2% باشد تا سختی مناسب برای تشکیل کلنیها (نه خیلی نرم که کلنیها پخش شوند و نه خیلی سخت که رشد محدود شود) فراهم گردد. انحراف حتی 0.1 گرم میتواند pH، غلظت osmolarity یا مغذی بودن را تغییر دهد. در موارد حساس، از مواد پودر آماده (dehydrated media) استفاده کنید و وزن را دو بار چک کنید. همچنین، مواد را بر اساس FIFO (First In, First Out) استفاده نمایید تا از انقضای آنها جلوگیری شود.
3. حل کردن مواد در آب: تکنیکهای مخلوط کردن
پس از توزین، مواد را به تدریج در آب گرم (معمولاً 40-60 درجه سانتیگراد) اضافه کنید تا از تشکیل توده یا رسوب جلوگیری شود. از همزن مغناطیسی (magnetic stirrer) یا ورتکس برای مخلوط کردن یکنواخت استفاده کنید و فرآیند را در هود لامینار انجام دهید تا از ورود ذرات هوا یا باکتریها جلوگیری گردد. برای محیطهای حاوی آگار، حرارت را به آرامی افزایش دهید تا آگار کاملاً حل شود (تا 100 درجه سانتیگراد)، اما از جوشاندن طولانی اجتناب کنید زیرا میتواند مواد مغذی حساس مانند ویتامینها یا پپتیدها را تجزیه کند. مثلاً در تهیه MacConkey Agar، کریستال ویوله و نمکهای صفراوی باید کاملاً حل شوند تا خاصیت سلکتیو حفظ شود. اگر رسوبی مشاهده شد، ممکن است به دلیل کیفیت پایین مواد یا pH نامناسب باشد؛ در این صورت، بچ را دور بیندازید. این مرحله معمولاً 10-20 دقیقه طول میکشد و باید با نظارت مداوم همراه باشد تا از بیشحرارت جلوگیری شود.
4. اندازهگیری و تنظیم pH: نقش pH در کیفیت محیط کشت میکروبی
pH محیط کشت عامل کلیدی در رشد میکروارگانیسمهاست و باید با pHمتر کالیبرهشده (با بافرهای استاندارد pH 4، 7 و 10) اندازهگیری شود. بیشتر محیطهای باکتریایی pH خنثی (6.8-7.2) دارند، اما محیطهای خاصی مانند محیطهای اسیدی برای Lactobacillus (pH 5.5) یا قلیایی برای Vibrio (pH 8.0) متفاوت هستند. تنظیم pH را پس از حل کامل مواد و قبل از استریلیزاسیون انجام دهید، زیرا حرارت میتواند pH را تغییر دهد (معمولاً کاهش دهد). از اسید هیدروکلریک 1N یا سدیم هیدروکسید 1N برای تنظیم استفاده کنید و تغییرات را به آرامی اعمال نمایید تا از نوسان جلوگیری شود. برای مثال، در TSI Agar، pH دقیق 7.3 برای تمایز فرمنتاسیون قندها ضروری است. اگر pH خارج از محدوده باشد، میتواند رشد باکتریها را مهار یا باعث نتایج کاذب در تستهای بیوشیمیایی شود. pH را پس از استریلیزاسیون نیز چک کنید و نتایج را در لاگبوک ثبت نمایید.
5. اضافه کردن مکملها: غنیسازی محیط کشت برای رشد باکتریایی
مکملهایی مانند خون، سرم، آنتیبیوتیکها، ویتامینها یا Tween 80 پس از خنک شدن محیط تا 45-50 درجه سانتیگراد اضافه شوند تا از تخریب حرارتی جلوگیری گردد. این مکملها برای حمایت از رشد باکتریهای فستیدیوس ضروری هستند؛ مثلاً در Chocolate Agar، خون حرارتدیده (برای آزادسازی فاکتورهای X و V) اضافه میشود تا Haemophilus رشد کند. مکملها باید استریل باشند و از فیلترهای 0.22 میکرونی عبور کنند. غلظت دقیق را رعایت کنید (مثلاً 5-10% خون در Blood Agar برای مشاهده همولیز) و از مخلوط کردن یکنواخت اطمینان حاصل نمایید. اگر مکملها کیفیت پایینی داشته باشند (مانند خون آلوده)، میتواند منجر به آلودگی یا رشد ضعیف شود. همیشه مکملها را از منابع معتبر تهیه کنید و تاریخ انقضای آنها را چک نمایید.
6. استریلیزاسیون: روشهای ضدعفونی در کنترل کیفی محیط های کشت
استریلیزاسیون برای حذف تمام میکروارگانیسمها ضروری است و معمولاً با اتوکلاو در 121 درجه سانتیگراد، 15 psi به مدت 15-20 دقیقه (بسته به حجم) انجام میشود. برای مواد حساس به حرارت مانند برخی آنتیبیوتیکها (مانند وانکومایسین) یا ویتامینها، از فیلتراسیون استریل با فیلترهای 0.22 میکرونی استفاده کنید. پس از استریلیزاسیون، محیط را به آرامی خنک کنید تا از تشکیل کریستال یا تغییر pH جلوگیری شود. اتوکلاو را با نوارهای نشانگر بیولوژیکی (مانند سویه Geobacillus stearothermophilus) تست کنید و چرخه را هر هفته کالیبره نمایید. بررسی کنید که محیط شفاف، بدون رسوب و با رنگ مناسب باشد. اگر استریلیزاسیون ناقص باشد، میتواند منجر به آلودگی بچ شود.
بررسیهای فیزیکی، شیمیایی و بیولوژیکی در ارزیابی کیفیت
کنترل کیفی باید برای هر بچ جدید (حداقل 10% از پلیتها یا تیوبها) انجام شود و شامل بررسیهای فیزیکی، شیمیایی، بیولوژیکی و عملکردی است. این فرآیند بر اساس ISO 11133 شامل استفاده از سویههای کنترل مثبت و منفی است.
بررسی فیزیکی و شیمیایی: پارامترهای ظاهری در کنترل کیفیت محیط کشت
این بررسی شامل ظاهر (شفافیت، رنگ، عدم رسوب)، سختی (برای محیطهای جامد، با فشار ملایم چک شود تا نه خیلی نرم باشد که کلنیها پخش شوند و نه خیلی سخت که رشد محدود گردد)، حجم (برای جلوگیری از تبخیر بیش از حد در اتوکلاو)، و osmolarity (با اسمومتر اندازهگیری شود) است. همچنین، تاریخ انقضا (معمولاً 1-3 ماه برای محیطهای آماده) و برچسبگذاری دقیق (شامل نام، تاریخ تولید، بچ و شرایط نگهداری) ضروری است. اگر محیط کدر باشد، ممکن است به دلیل رسوب مواد یا آلودگی باشد؛ در این صورت، بچ را رد کنید.
بررسی استریلیتی: کنترل آلودگی در محیط های کشت میکروبی
برای بررسی استریلیتی، حداقل 5% از بچ را در انکوباتور 35-37 درجه سانتیگراد به مدت 48-72 ساعت قرار دهید. هیچ رشدی نباید مشاهده شود. اگر آلودگی رخ داد (مانند رشد قارچ یا باکتری)، منبع را ریشهیابی کنید (آب، ابزار یا هوا) و بچ را دور بیندازید. تستهای دورهای با نشانگرهای شیمیایی یا بیولوژیکی نیز توصیه میشود.
ارزیابی عملکرد مغذی بودن: تست رشد باکتری در کنترل کیفی
این بخش بررسی میکند که آیا محیط مواد مغذی کافی (مانند کربوهیدراتها، پپتونها و ویتامینها) برای رشد باکتریهای مورد نظر فراهم میکند. از سویههای استاندارد ATCC مانند E. coli ATCC 25922 برای Nutrient Agar استفاده کنید. محیط را با تلقیح 10-100 CFU تلقیح کنید، در شرایط مناسب (دما، اتمسفر) انکوبه نمایید و رشد را از نظر تعداد کلنیها (باید بیش از 70% recovery باشد)، اندازه، مورفولوژی و زمان رشد (معمولاً 18-24 ساعت) ارزیابی کنید. اگر رشد ضعیف باشد، ممکن است به دلیل کمبود مغذی، pH نامناسب یا تخریب حرارتی باشد. برای محیطهای غنیشده مانند Blood Agar، همولیز را چک کنید. این ارزیابی باید با کنترل مثبت و منفی انجام شود و نتایج در چکلیست ثبت گردد.
ارزیابی عملکرد مهاری: مهار رشد ناخواسته در محیط کشت
این بخش بررسی میکند که آیا محیط رشد باکتریهای ناخواسته را مهار میکند در حالی که باکتریهای هدف رشد میکنند. برای محیطهای سلکتیو مانند MacConkey Agar، از سویههای کنترل منفی (مانند S. aureus که نباید رشد کند) و مثبت (E. coli که رشد میکند) استفاده کنید. غلظت مهارکنندهها (مانند نمک در Mannitol Salt Agar یا آنتیبیوتیک در Mueller Hinton) را چک کنید. اگر رشد ناخواسته رخ داد، ممکن است غلظت مهارکننده کم باشد یا محیط تخریب شده باشد. ارزیابی را با تلقیح استاندارد انجام دهید و پس از 24-48 ساعت بررسی کنید.
در بخش ارزیابی کیفیت از نظر رشد و عدم رشد باکتریها، جدول زیر مثالهایی از محیطهای کشت رایج را نشان میدهد. این جدول بر اساس دادههای استاندارد میکروبیولوژی و نتایج آزمایشگاهی تهیه شده است و برای هر آزمایشگاه، باید با سویههای کنترل آزمایش شود:
| نام محیط کشت | باکتریهایی که رشد میکنند | باکتریهایی که رشد نمیکنند |
|---|---|---|
| Nutrient Agar | باکتریهای غیرفستیدیوس مانند E. coli, Staphylococcus aureus | باکتریهای فستیدیوس مانند Neisseria gonorrhoeae (نیاز به مکمل دارند) |
| MacConkey Agar | Gram-negative مانند E. coli, Enterobacteriaceae | Gram-positive مانند Staphylococcus, Streptococcus |
| Mannitol Salt Agar | Staphylococci (مانند S. aureus) | بیشتر باکتریهای دیگر به دلیل غلظت بالای نمک |
| Blood Agar | بسیاری از باکتریها مانند Streptococcus, Staphylococcus | برخی باکتریهای آناروبیک سخترشد بدون مکمل |
| EMB Agar | Enterobacteriaceae مانند E. coli, Klebsiella | Gram-positive و برخی Gram-negative غیرانتروباکتریاسه |
| Mueller Hinton Agar | باکتریهای غیرفستیدیوس مانند E. coli, S. aureus, P. aeruginosa | باکتریهای فستیدیوس مانند Neisseria, Haemophilus, anaerobes |
| Bile Esculin Agar | Enterococci مانند E. faecalis, Listeria monocytogenes | Streptococcus pyogenes, most Gram-negatives |
| SIM Agar | Enterobacteriaceae مانند E. coli, Salmonella | Some strict aerobes or anaerobes |
| XLD Agar | Salmonella, Shigella, some Enterobacteriaceae | Gram-positive bacteria, most non-enteric |
| Malonate Broth | Enterobacter, Klebsiella (که malonate استفاده میکنند) | E. coli (رشد میکند اما نتیجه منفی)، non-enteric |
| Nutrient Broth | باکتریهای غیرفستیدیوس مانند E. coli, S. aureus | باکتریهای فستیدیوس مانند Neisseria |
| Phenol Red Agar/Broth with Carbohydrates | Gram-negative enteric که کربوهیدرات فرمنت میکنند مانند E. coli | Non-fermenters یا non-enteric |
| Phenylalanine Agar | Proteus, Providencia, Morganella | E. coli, Klebsiella (رشد میکنند اما نتیجه منفی) |
| Triple Sugar Iron (TSI) Agar | Enterobacteriaceae مانند Salmonella, Shigella, E. coli | Non-fermenters, Gram-positive |
| Urea Agar/Broth | Proteus, Klebsiella (که urease تولید میکنند) | E. coli (رشد میکند اما نتیجه منفی)، non-urease producers |
| Chocolate Agar | Fastidious مانند Haemophilus, Neisseria, نیز non-fastidious | Some that require specific factors, but generally supportive |
| Bismuth Sulfite Agar | Salmonella (black colonies), some Shigella | Gram-positive, coliforms, many enteric |
موارد دیگر در کنترل کیفی: ذخیرهسازی و استانداردهای محیط کشت میکروبی
- ذخیرهسازی: محیطها را در یخچال 2-8 درجه سانتیگراد یا در تاریکی نگهداری کنید تا از تخریب نوری یا حرارتی جلوگیری شود. از ظروف استریل استفاده کنید و از انباشت بیش از حد اجتناب نمایید. محیطهای حساس مانند Chocolate Agar را حداکثر 2 هفته نگهداری کنید.
- کنترل آلودگی: همیشه در هود لامینار کار کنید، ابزارها را استریل نگه دارید و از PPE (Personal Protective Equipment) استفاده نمایید. تستهای هوا و سطوح آزمایشگاه را ماهانه انجام دهید.
- استانداردها و مستندسازی: هر بچ را با چکلیست ISO 11133 یا CLSI M22 مقایسه کنید. در صورت شکست QC، علت را با روش 5-Why ریشهیابی کنید و گزارش دهید.
- بررسی دورهای تجهیزات: اتوکلاو، انکوباتور و pHمتر را کالیبره کنید و لاگ نگهداری داشته باشید.
نتیجهگیری
کنترل کیفی محیط کشت یک فرآیند حیاتی و مداوم است که تضمینکننده دقت و قابلیت اعتماد نتایج آزمایشگاهی میباشد. کارشناسان آزمایشگاه باید آموزش مداوم ببینند، از چکلیستهای استاندارد استفاده کنند و سیستم QA/QC را پیادهسازی نمایند. با رعایت این اصول، میتوان از خطاهای احتمالی جلوگیری کرد، کیفیت را ارتقا داد و به استانداردهای جهانی دست یافت. برای اطلاعات بیشتر، به منابع مانند CLSI یا ISO مراجعه کنید.
سوالات رایج
1. کنترل کیفی محیط های کشت میکروبی چیست؟
کنترل کیفی محیط های کشت میکروبی فرآیندی است که شامل بررسی مواد اولیه، تهیه، استریلیزاسیون و ارزیابی عملکرد محیط برای اطمینان از رشد صحیح میکروارگانیسمها و جلوگیری از آلودگی است، بر اساس استانداردهای CLSI و ISO.
2. چرا کنترل کیفی محیط های کشت میکروبی مهم است؟
این کنترل برای دقت نتایج آزمایشگاهی، جلوگیری از نتایج کاذب، تشخیص صحیح بیماریها و رعایت استانداردهای کیفیت در آزمایشگاههای میکروبیولوژی ضروری است، زیرا نقص در محیط میتواند منجر به رشد نادرست باکتریها شود.
3. آب مورد استفاده در محیط های کشت میکروبی باید چه کیفیتی داشته باشد؟
آب باید مقطر یا دیونیزه با مقاومت الکتریکی حداقل 1 مگااهم، pH 5.5-7.5، عاری از باکتریها و اندوتوکسینها باشد و قبل از استفاده فیلتر شود تا از تأثیر منفی بر رشد باکتریها جلوگیری شود.
4. چگونه pH محیط کشت را در کنترل کیفی تنظیم کنیم؟
pH را با pHمتر کالیبرهشده اندازهگیری کرده و با اسید هیدروکلریک یا سدیم هیدروکسید تنظیم کنید؛ معمولاً 6.8-7.2 برای محیطهای باکتریایی، و پس از استریلیزاسیون دوباره چک شود.
5. روشهای استریلیزاسیون محیط های کشت میکروبی چیست؟
استریلیزاسیون با اتوکلاو در 121 درجه سانتیگراد به مدت 15-20 دقیقه یا فیلتراسیون برای مواد حساس به حرارت انجام میشود، و باید با نشانگرهای بیولوژیکی تست شود.
6. ارزیابی عملکرد مغذی بودن محیط کشت چگونه انجام میشود؟
با تلقیح سویههای استاندارد مانند E. coli ATCC 25922 و بررسی تعداد کلنیها، اندازه و مورفولوژی پس از انکوباسیون، برای اطمینان از تأمین مواد مغذی کافی.
7. ارزیابی عملکرد مهاری در کنترل کیفی محیط های کشت چیست؟
بررسی مهار رشد باکتریهای ناخواسته با استفاده از سویههای کنترل منفی، مانند مهار Gram-positive در MacConkey Agar، برای تأیید خاصیت سلکتیو محیط.
8. سویههای کنترل استاندارد در کنترل کیفی محیط های کشت میکروبی کدامند؟
سویههای ATCC مانند E. coli 25922، S. aureus 25923 و P. aeruginosa 27853 برای تست عملکرد مغذی و مهاری استفاده میشوند.
9. چگونه محیط های کشت میکروبی را ذخیره کنیم؟
در یخچال 2-8 درجه سانتیگراد، در تاریکی و ظروف استریل نگهداری شود، با تاریخ انقضا 1-3 ماه، و بر اساس FIFO استفاده گردد تا از تخریب جلوگیری شود.
10. علل رایج شکست در کنترل کیفی محیط های کشت میکروبی چیست؟
علل شامل کیفیت پایین آب، توزین نادرست، حرارت بیش از حد، آلودگی ابزارها، pH نامناسب یا ذخیرهسازی طولانی است که میتواند منجر به رشد ضعیف یا آلودگی شود.
جهت مطالعه بیشتر به لینک زیر مراجعه کنید:
